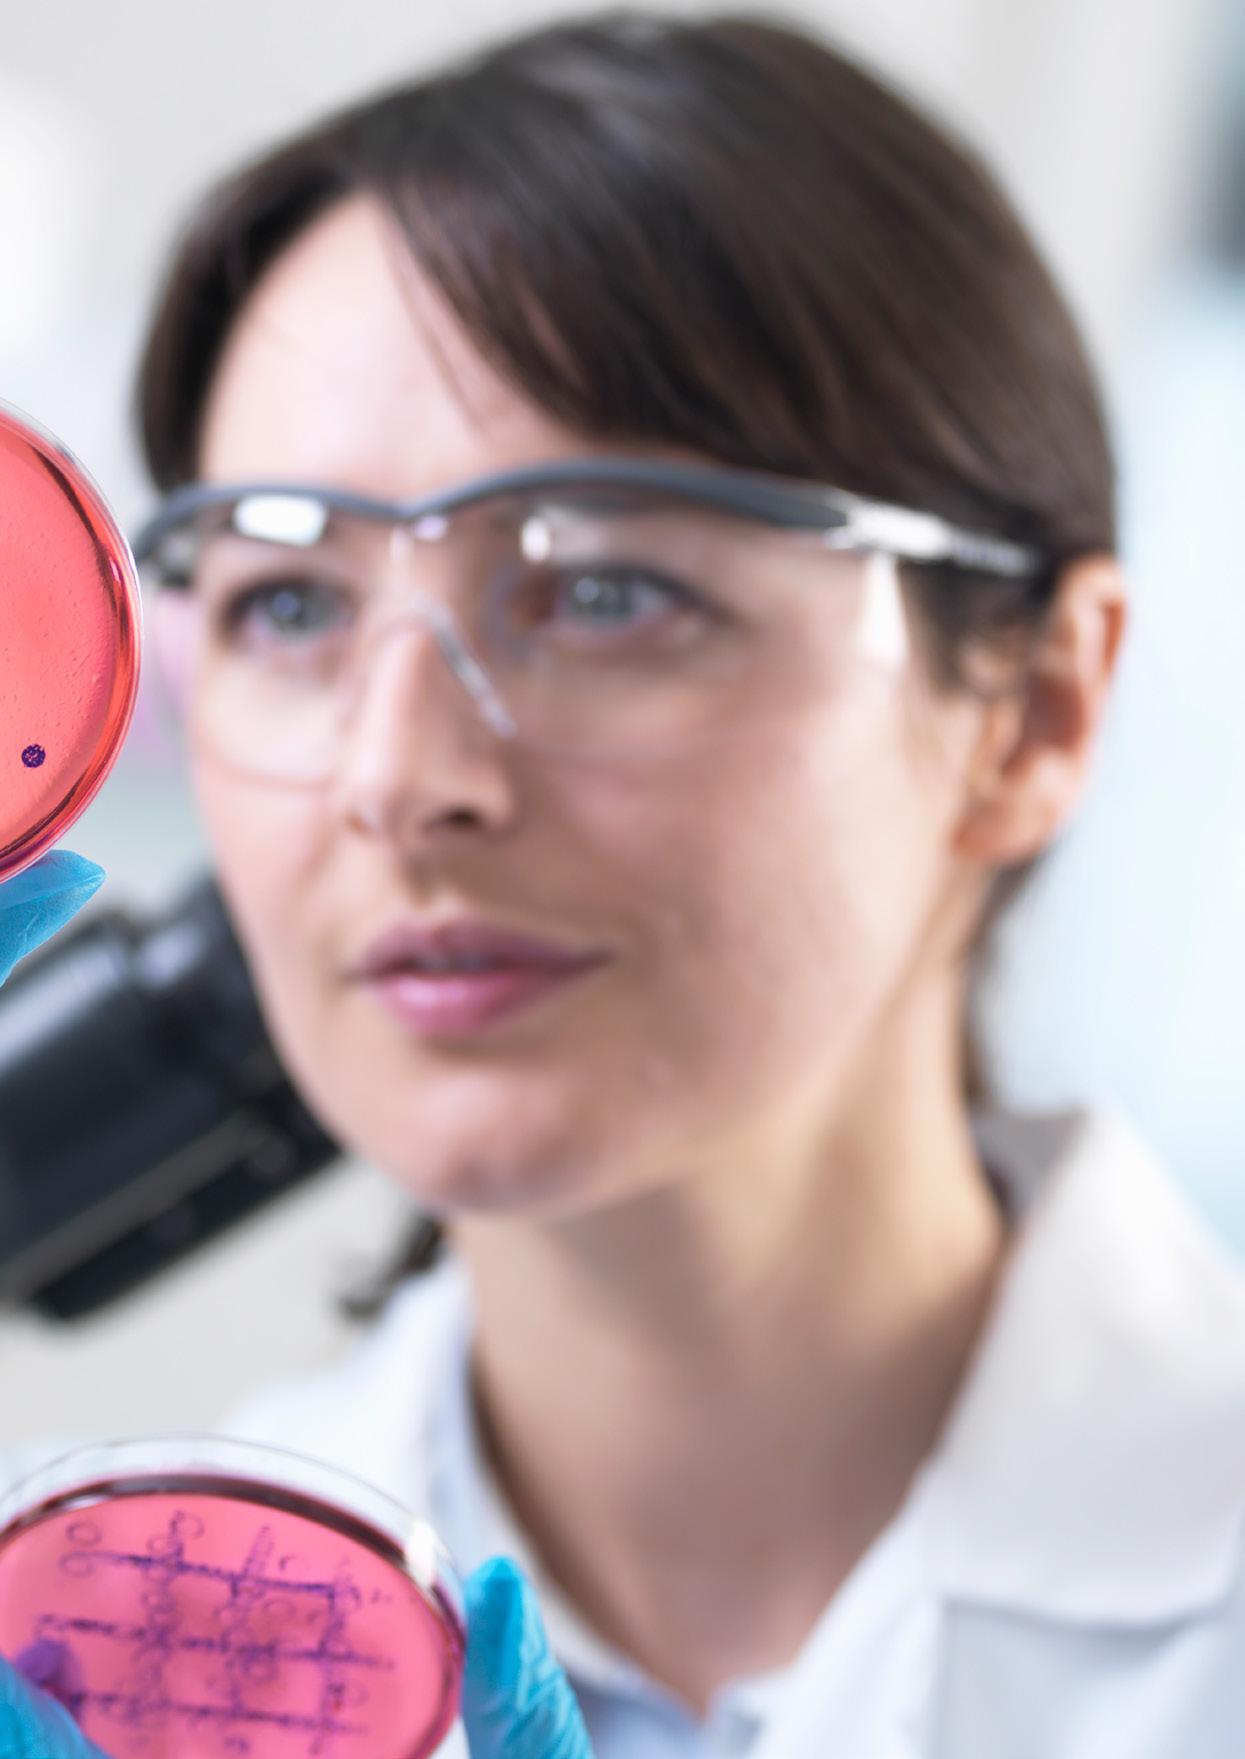

Michigan Medicine Innovating With Cloud Transformation

WRITTEN BY: MARCUS LAW
PRODUCED BY: TOM VENTURO
Based in Ann Arbor, Michigan, and part of one of the world’s leading universities, Michigan Medicine is a premier, highly ranked academic medical centre and award-winning health care system with state-of-the-art facilities.
As its CTO Tim Calahan explains, as a toptier academic institution Michigan Medicine has the ability to significantly move the needle, not just for people within the State of Michigan, but throughout the world.
“We have a vision here at Michigan Medicine to deliver great care and train exceptional physicians, but also deliver that care throughout the State of Michigan in order to deliver that care and make those improvements globally,” Calahan describes.
With extensive experience in developing innovative solutions, specifically helping and assisting healthcare organisations moving to the cloud, Tim Calahan is CTO at Michigan Medicine, responsible for managing much of the technology that the organisation is putting in place.
One key area Michigan Medicine will be focusing on in this transformation is the moving of its Epic infrastructure to the cloud. One of the more complicated applications within a healthcare system’s ecosystem is Epic, which was not originally designed to run in the cloud. As Calahan describes, the decision to host healthcare records software

“We have a vision here at Michigan Medicine to deliver good care and train exceptional physicians, but also deliver that care throughout the State of Michigan”
DR TIM CALAHAN, CHIEF TECHNOLOGY OFFICER, MICHIGAN MEDICINE


“We want to make sure that the technology solutions really match up to the business needs and the business drivers”
DR TIM CALAHAN, CHIEF TECHNOLOGY OFFICER, MICHIGAN MEDICINE
Epic in the cloud when he was working at EMC was at the time controversial.
“Epic at the time were actually telling their customers they had to stay on-prem,” Calahan says. “So we were able to provide some very innovative solutions in terms of how to move Epic out of the data centre. As part of that journey we have really shifted the market in opening their eyes to the fact that organisations didn’t have to maintain these internal data centres and that they could move things safely to the cloud.
“What brought me to the role here is Michigan Medicine has a strong desire to modernise their infrastructure, modernise how they do business and leverage cloud

much more heavily and distinctly than they do today. Here at Michigan Medicine, they want to move everything to the cloud, and because of that desire and the alignment to that mission, I readily accepted the role and the position. We’ve been hard at work in mapping out what that would look like here for Michigan Medicine, and we’re just now beginning to start that journey ourselves in moving workloads to the cloud.”
As Calahan describes, to be able to shift the mindset of an entire industry has been a particular achievement.
“When we started hosting Epic in the cloud, we realised it would be disruptive, but we also realised that this could be very

innovative to our healthcare customers. And interestingly, it was also what our customers were asking for. In my management consulting days, my customers were highly annoyed by not being able to move Epic to the cloud or not being able to move their workloads to the cloud. They were begging for a path to execute and move things out of their internal data centres and into the cloud, because they realised some of the value that that could bring.
“As we started down that journey we were told by numerous people it wouldn’t work and that we wouldn’t be able to do it – including by Epic themselves. But fastforward to now and we’ve moved the
industry. Now Epic fully embraces running Epic in the public cloud. We have reference architecture in Azure, in AWS and in GCP in terms of how to run that application in the cloud, and we now have general acceptance by the industry at large.”
From two decades ago when healthcare records were delivered with paper and pen, the advent of electronic health records – driven by major players Epic and Cerner – has changed the landscape. Now, with these records moving to the cloud, Calahan explains how the industry is at a pivotal point.

“By moving things to the cloud, I have the ability to scale compute and storage up and down in a very responsible way that I can’t do on-prem”
DR TIM CALAHAN, CHIEF TECHNOLOGY OFFICER, MICHIGAN MEDICINE

“When you move electronic health records to the cloud, you’re connecting it to all of the cloud’s products and services like large scale data fabric and data warehousing capabilities, that healthcare institutions don’t have the skills and capabilities to build on-prem.
“We’ve all heard the buzz around generative AI (Gen AI), particularly in 2023. By placing Epic in the cloud, we now set it next to things like Gen AI. This allows us to change how we deliver patient care and how we deliver a patient experience. By moving it into the cloud, we enable those broader suites of features and functionality that the cloud provides.”
Running Epic in the cloud also provides other benefits, particularly when it comes to scalability, to better meet the compute and storage needs of healthcare organisations.
“We’ve got about 14,000 users here at Michigan Medicine,” Calahan says. “On a
Monday morning at 10AM, I’ve got about 14,000 users hitting our Epic system. But on Monday at 2AM, I might only have 1,000. By moving things to the cloud, I have the ability to scale compute up and down in a very responsible way that I can’t do on-prem.”
Another benefit of moving Epic to the cloud is that it enables standardisation of compute infrastructure, providing cost efficiencies and better performance.
“If you’re a healthcare organisation, every six months Epic comes and needs to do an upgrade. So then you get these surprise multimillion dollar infrastructure investments where you have to buy more compute and more storage, which is challenging from a budgeting perspective.
“But from a technology perspective, what it means is your Epic environment, which is the most important application that you have within your healthcare system, has essentially been cobbled together over
LEVERAGING CLOUD TO DELIVER OPERATIONAL EFFICIENCIES AND AGILITY.
See what NetApp can do for you →

Michigan Medicine is joining other leading healthcare organizations in expanding its use of cloud for right - sizing compute and storage capacity on - demand.
This improved agility delivers cost efficiency, with the added benefit of enhanced cyber resiliency.
Finding the right technology partner is step one.
MM chose NetApp.

Managing 2.6 million patient visits every year requires not just innovative healthcare delivery. It requires an equally innovative technology strategy. At Michigan Medicine, that took the form of an IT modernization vision to drive transition to the cloud – and maintain steady-state operations thereafter.
The goal: improve operational efficiencies and agility, while strengthening data assurance and resiliency.
The partner? NetApp.
Tim Calahan, Michigan Medicine CTO, explains, “There are a variety of reasons hosting EHR in the cloud makes great sense to a healthcare organization. Cloud can deliver business agility or ‘speed,’ and the ability to scale and right-size the environment. We plan to move our Epic environment to the cloud, as well as our imaging application and the rest of our general purpose workloads.
“NetApp has a very strong public cloud strategy and portfolio, and provides enterprise storage product offerings in all of the major public clouds – which we’ll leverage for DR and Epic. This will require an enterprise storage platform with the ability to move data from on-premise environments to the cloud. NetApp provides a single, consistent management plane for all storage assets, across both on-prem and cloud.
“Through those migrations, we will have made significant progress in moving out of the data center business… and yielding the resulting cost efficiencies,” he says.
The MM plan also addresses the pressing issue of cyber resiliency, improving on the traditional backup and recovery processes in use today. “Our ability to provide a much more streamlined and efficient recovery method will improve resiliency. By injecting backup and recovery capabilities into the very foundation of our cloud operating platforms, we will expand our capability for identifying and recovering from a cyber event,” Calahan concludes.
He advises, “Proper planning is essential. A complete technology inventory can provide invaluable insights into how to best structure a move to cloud. Have well-defined technology requirements and choose your partner wisely. Technology matters.”

the years, because every six months you’re buying new compute or you’re increasing storage. If you have the ability to standardise the chip set or the compute infrastructure that delivers Epic, that would yield better performance, and you can do that in the cloud.
“If I don’t have to cobble everything together, I can deliver better performance back to my end users, which translates to a better experience for everyone around.”
Another benefit of moving to the cloud, Calahan adds, is increased protection and recoverability when it comes to a cyber event.
“There is not a week that goes by that you don’t hear about a healthcare system suffering from a cyber attack. One of the goals of our cloud initiative is to enhance and improve upon the very traditional backup and recovery processes and procedures we use today to provide a much more streamlined and efficient method to perform recovery, which will thereby improve resiliency. We aim to inject backup and recovery capabilities into the very foundation of our cloud operating platforms, which will make it capable at identifying and recovering from a cyber event.”
Partnerships: Microsoft and NetApp
Viewing partnerships as critically important, Calahan describes how Michigan Medicine relies on different partners to bring their skill sets and expertise in terms of what the art of the possible is as it relates to their products and solutions.
“In 30 years in healthcare and in 10 years at Dell EMC, I’ve seen a lot of technology products and solutions. And because I have 15 years of management consulting,

I’m very unbiased,” he says. “We want to make sure that the technology solutions really match up to the business needs and the business drivers.”
One of Michigan Medicine’s valued partners, Microsoft, has proven particularly effective at creating products and solutions that are meaningful to the organisation.
“We’ve leveraged Office 365 and moved email and SharePoint out into the cloud,” Calahan says. “And we’ve started to build out cloud infrastructure for things like Epic Cloud Read Only, a disaster recovery capability that we can perform in the cloud much more effectively than on-prem.
“Microsoft’s been super helpful at that, and at showing us some of the newer

“What brought me to the role here is Michigan Medicine has a strong desire to modernise their infrastructure, modernise how they do business and leverage cloud much more heavily”
DR TIM CALAHAN, CHIEF TECHNOLOGY OFFICER, MICHIGAN MEDICINE

technologies that are coming out in terms of their data fabric and also their Gen AI capabilities, that will be very meaningful to us as we begin to move things out in the cloud and be able to take advantage of those tools and products and solutions.”
Another of its partners, NetApp, has helped Michigan Medicine by providing a single management plane to leverage on-premise and cloud assets.
“When we look at things like hosting Epic, if I want to host it in the cloud, I can do that on NetApp storage and I can have a common management plane between those two environments that makes it easier to manage. It means I can manage it the same way, whether it’s on-prem or in the cloud.
“When I came into the role, the organisation had just finished doing a cloud assessment. Unfortunately, the assessment couldn’t map data back to individual workloads. So NetApp was able to come in and provide a cloud insights assessment to paint a very clear picture of what those environments look like.
“I’ve been in the industry a long time and you hear about people that have made a move to the cloud, but they didn’t really have a plan in terms of how they were going to execute on that. And I’ve seen or I’ve heard of organisations that have signed these massive cloud contracts, but without the underlying plan to execute on that cloud contract.”
Tim CalahanTITLE: CHIEF TECHNOLOGY OFFICER
Dr. Tim Calahan is renowned for his expertise in hosting Epic on the cloud. With a solid engineering background, two Master’s degrees, and a Doctorate, he excels at fostering innovation and leading transformative change. Dr. Calahan is known for creating structure from chaos, driving innovation, charting new strategies, effectively communicating visionary ideas and directing technical teams to success. Recognized for rescuing technology projects and setting strategic roadmaps for digital transformation, his extensive expertise lies in cloud transformation, including hosting Epic on the cloud. Dr. Calahan brings over 30 years of professional experience with over 25 years in Healthcare and 15 years in Management Consulting.
With planning IT needs being so important, NetApp was helpful in mapping out Michigan Medicine’s resources, enabling us to then create a plan as to how it would move to the cloud.
“We’re a public institution, so we had to issue a series of RFPs,” Calahan says. “When we issued those RFPs, we had to be very specific in terms of how much compute and storage we were going to need. We’ve heard that that’s very rare in the industry, but through our partners like Microsoft and NetApp, we could be very specific in terms of what we needed and what our anticipated journey might look like.”
As Calahan describes, in the near future the focus at Michigan Medicine will be on transitioning a significant portion of the organisation’s operational processes to cloud-based systems through a lift and shift methodology.




Once this transition is underway, the organisation will be able to harness exciting technologies, such as Gen AI. As Michigan Medicine progresses with the cloud migration, the challenges and opportunities lie in harnessing these emergent technologies – particularly Gen AI – in a meaningful and operational manner.
“Gen AI has been eye opening in terms of its potential impact to the business, and there’s been a lot of justifiable excitement around that particular type of technology. Unfortunately, in 2023, there was a lot of talk about the potential, but there wasn’t a lot of talk in terms of what we were actually executing on. And because there wasn’t the talk about execution, there also wasn’t the talk about how to operationalise any of it.
“So what I look forward to as we begin to move things out in the cloud is how we
take advantage of some of these tools and technologies that people are talking about.”
“Once we’ve moved things out into the cloud, the next series of journeys will be how do we take workloads that are operating in the cloud and use more cloud native tools and solutions to enhance patient care or improve the patient experience. That’s where it gets really exciting for me.
“Then we will really have the opportunity to elevate the institution in terms of providing a brand new set of tools and technologies that we don’t have in our on-prem environment. And that’s where the excitement will really begin to pick up speed and momentum.”